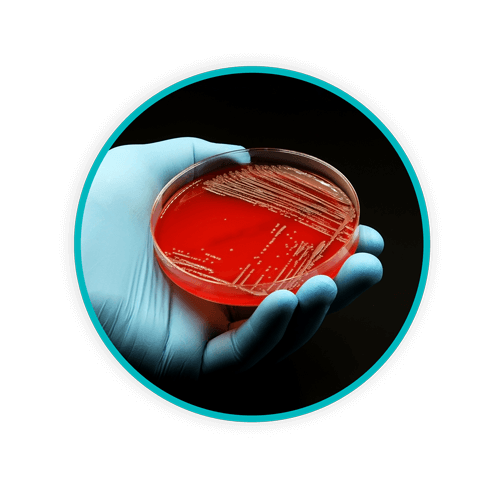
Blog Circle BPP DANUSB241011 WEB

How Healthcare Facilities Can Reduce Risk of Exposure to Bloodborne Pathogens

The healthcare setting is an environment that has many occupational safety issues, and these hazards are not encountered just by healthcare workers. Other disciplines that work in healthcare – such as maintenance, housekeeping, dietary, and other ancillary services – are also at risk to workplace hazards. This is certainly the case when it comes to potential exposure to bloodborne pathogens (BBP).
TOPICS WE WILL COVER:
1 / Where are bloodborne pathogens encountered?
2 / What are some common types of bloodborne pathogens?
3 / Implementing an Exposure Control Plan
4 / How regulated medical waste fits into the picture
Where are bloodborne pathogens encountered?
The Occupational Safety and Health Administration (OSHA) defines BBP as “infectious microorganisms in human blood that can cause disease in humans.” These pathogens are not only found in blood but can also be found in Other Potentially Infectious Material (OPIM).
BBP can be encountered anywhere in the healthcare environment. The most common BBP exposure to workers in a healthcare setting is through a puncture in the skin or from a cut or injury. This can be through an accidental needlestick or a cut from an instrument after use on a patient. BBP exposure could also occur when splashing to the eyes, nose, or mouth occurs.
Another everyday BBP exposure is through improper handling of regulated waste. All workers in healthcare encounter regulated waste, and the healthcare setting has specific regulations regarding handling regulated waste due to the nature of its contents. Without proper engineering controls like safe disposal containers, the risk for BBP exposure during disposal is heightened.
What are some common types of bloodborne pathogens?
The three most common BBPs include human immunodeficiency virus (HIV), hepatitis B (HBV), and hepatitis C (HCV). The consequences of exposure are immense:
HIV
- Disables the body’s immune system until it can no longer fight infection.
- The person infected with HIV becomes more vulnerable to types of pneumonia, intestinal disorders, and fungal infections.
- Most of the documented cases of possible cases of HIV transmission to US healthcare workers involve nurses and lab technicians.
- Most of the cases were associated with percutaneous injury (puncture/cut injury).
- There is not an HIV vaccine.
HBV
- Causes severe liver damage and death.
- Symptoms include jaundice, fever, nausea, and abdominal pain.
- The chance of becoming infected with hepatitis B from a sharp injury is estimated to be between six and 30 percent.
- There has been a decline in healthcare worker HBV infection since the 1980s due to widespread immunization of healthcare workers with the hepatitis B vaccine and the use of universal precautions and other measures required by OSHA.
HCV
- Causes serious damage to the liver and can be fatal.
- Infection can occur without symptoms or only mild ones.
- Healthcare workers exposed to blood in the workplace account for two to four percent of the total acute HCV infections.
- There is no HCV vaccine.
Implementing an Exposure Control Plan
Healthcare employers must implement an exposure control plan with details on employee protection measures. The plan comprises a multidisciplinary approach that should include, at a minimum, stakeholders from the occupational health and infection prevention and control departments.
The plan should include all job positions potentially exposed to BBP during work tasks. Some job positions may have a risk hazard applied, so training and details will be performed appropriately. OSHA’s BBP standard describes in detail what the exposure control plan should entail.
Engineering and Work Practice Controls
- Engineering and work practice controls eliminate or minimize employee exposure
- Examples include safer medical devices, such as needless devices, shielded needle devices, plastic capillary tubes, and safer disposal containers.
Personal Protective Clothing and Equipment
- These include gloves, gowns, face shields or masks, eye protection, and other protective gear.
- The level and type of protection must fit the expected exposure.
Employee Training
- Employers must ensure that their workers receive regular training that covers BBP.
- Employers must offer this training on initial assignment, at least annually thereafter, and when new or modified tasks or procedures are introduced.
Medical Surveillance
- The employer must implement protection protocols if a worker is exposed to BBP.
- This includes care for the worker, documentation, a post-exposure visit with a provider, and follow-up.
Hepatitis B Vaccinations
- Employers must offer the hepatitis B vaccination series to all workers who have occupational exposure.
- The vaccine and vaccination must be offered to the worker at no cost and at a reasonable time and place.
How regulated medical waste fits into the picture
Exposure to regulated waste is a risk for individuals working in healthcare. The OSHA BBP standard uses the term “regulated waste” to refer to the following categories of waste that require special handling:
- Liquid or semi-liquid blood or OPIM;
- Items contaminated with blood or OPIM and which would release these substances in a liquid or semi-liquid state if compressed;
- Items that are caked with dried blood or OPIM and are capable of releasing this material during handling;
- Contaminated sharps;
- Pathological and microbiological wastes blood or OPIM.
Employers must include how regulated waste is managed in their exposure control plan. This includes providing the resources to dispose of regulated waste safely, such as biohazard receptacles and sharps disposal containers. Healthcare workers are not the only individuals that may suffer a needlestick injury. There have been cases where housekeeping staff has sustained a needlestick injury due to needles being disposed of in regular trash receptacles and linen receptacles.
Regulated waste is also handled by maintenance staff when it is moved from one location to another. The transportation of regulated waste throughout the facility and on the roadways has unique requirements. State and local regulations, along with the Department of Transportation regulations, must be followed for safety concerns.
BBP are of great concern when working in a healthcare setting. Safety considerations should be a priority for the employer, and the employees require compliance to increase safety awareness. Education on proper handling and prevention of BBP will make a difference for any organization. The main goal is safety for all.
References:
- Centers for Disease Control and Prevention [CDC]. 2019. National Occupational Research Agenda (NORA). https://www.cdc.gov/nora/councils/hcsa/stopsticks/bloodborne.html
- Centers for Disease Control and Prevention [CDC]. 2023. The National Institute for Occupational Safety and Health [NIOSH]. Bloodborne Infections Diseases: HIV/AIDS, Hepatitis B, Hepatitis C. https://www.cdc.gov/niosh/topics/bbp/default.html
- Centers for Disease Control and Prevention [CDC]. 2023. Infection Control. Occupationally-acquired infections in healthcare settings. https://www.cdc.gov/infection-control/hcp/safety/index.html
- Centers for Disease Control and Prevention [CDC]. National center for HIV, viral hepatitis, STD, and TB Prevention. 2023. https://www.cdc.gov/nchhstp/index.html
- Occupational Safety and Health Administration [OSHA]. Bloodborne pathogens and needlestick prevention. https://www.osha.gov/bloodborne-pathogens
- Occupational Safety and Health Administration [OSHA]. Standard 1910.1030 – Bloodborne pathogens. https://www.osha.gov/laws-regs/regulations/standardnumber/1910/1910.1030
Let's Talk!
Your time is valuable, and we don’t want to play hard to get. You can either phone us directly on the details listed on our contact page, or feel free to fill out this short form and one of our team members will get back to you as quickly as possible.